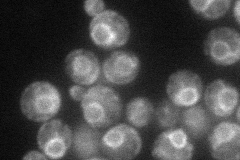
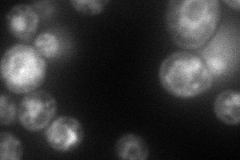
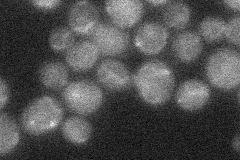
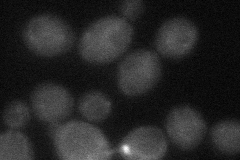
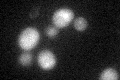
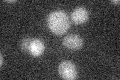

View description
Palmitoyltransferase with autoacylation activity, required for palmitoylation of amino acid permeases containing a C-terminal Phe-Trp-Cys site; required for modification of Chs3p; member of the DHHC family of putative palmitoyltransferases
Localization:
Intensity:
Fold change:
Significance:
-
C’ GFP library in SD

below threshold14.41 -
N' NOP1pr-GFP in SD
ER50.2566 -
N' TEF2pr-mCherry in SD
ER,vacuole62.7536 -
N' NATIVEpr-GFP in SD
below threshold18.4599 -
N' TEF2pr-VC and Cyto-VN in SD
below threshold29.936 -
C’ GFP library in SD+DTT
cytosol151.04No -
C’ GFP library in SD+H2O2

cytosol14.150.98No -
C’ GFP library in Starvation Media
cytosol16.681.15No -
C’ GFP library on the background of Pup2-DaMP

N/A -
C’ GFP library on the background of CCT mutant

N/A0N/AYes
